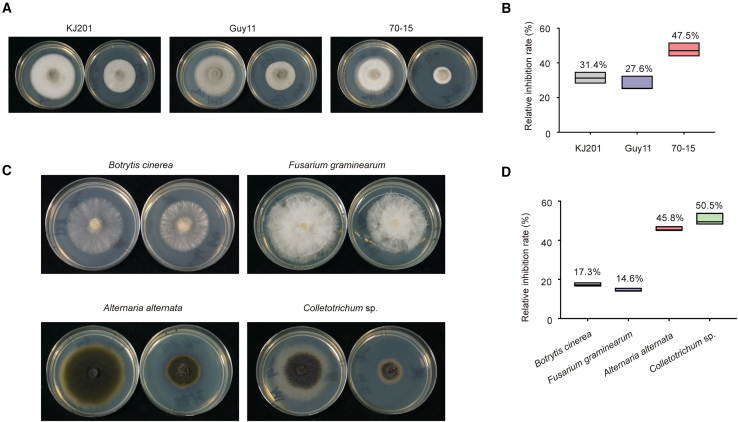
Figure 6

Abstract
Rice blast is a devastating disease worldwide, threatening rice production and food security. The blast fungus Magnaporthe oryzae invades the host via the appressorium, a specialized pressure-generating structure that generates enormous turgor pressure to penetrate the host cuticle. However, owing to ongoing evolution of fungicide resistance, it is vitally important to identify new targets and fungicides. Here, we show that Trs85, a subunit of the transport protein particle III complex, is essential for appressorium-mediated infection in M. oryzae. We explain how Trs85 regulates autophagy through Ypt1 (a small guanosine triphosphatase protein) in M. oryzae. We then identify a key conserved amphipathic α helix within Trs85 that is associated with pathogenicity of M. oryzae. Through computer-aided screening, we identify a lead compound, SP-141, that affects autophagy and the Trs85–Ypt1 interaction. SP-141 demonstrates a substantial capacity to effectively inhibit infection caused by the rice blast fungus while also exhibiting wide-ranging potential as an antifungal agent with broad-spectrum activity. Taken together, our data show that Trs85 is a potential new target and that SP-141 has potential for the control of rice blast. Our findings thus provide a novel strategy that may help in the fight against rice blast.
Key words: Magnaporthe oryzae, rice blast, TRAPPIII complex, trs85, fungicide
This study reveals the mechanism by which the Trs85–Ypt1 module regulates autophagy in M. oryzae. Based on the structure of Trs85, a lead antifungal compound, SP-141, has been identified through virtual screening. This inhibitor affects autophagy and shows great potential for control of rice blast.
Introduction
Plant pathogenic fungi are responsible for many of the most devastating crop diseases and pose constant threats to global food security. In particular, the rice blast pathogen Magnaporthe oryzae causes widespread and severe rice disease (Talbot, 2003). Numerous studies have revealed the detailed mechanism of the M. oryzae infection process. Rice blast fungus enters the host plant using a specialized pressure-generating structure called an appressorium, which ruptures the leaf cuticle via tremendous physical force (Talbot, 2003; Ryder and Talbot, 2015). By accumulating high concentrations of glycerol and other polyols, the appressorium generates turgor pressure of up to 8.0 MPa (de Jong et al., 1997). In addition, the melanin-rich differentiated cell wall acts as a rigid structural barrier to prevent solute efflux and thus plays a crucial role in the generation of turgor pressure (Howard et al., 1991; de Jong et al., 1997). The mechanical force generated by turgor pressure in the appressorium leads to production of a narrow penetration peg, which then breaches the cuticle of the rice leaf (Talbot, 2003). When the invasive mycelium enters the leaf, it rapidly colonizes the first epidermal cell and invades neighboring cells through plasmodesma-rich pit fields (Sakulkoo et al., 2018).
Macroautophagy (hereafter called autophagy) is a lysosome/vacuole degradation pathway characterized by the formation of double-membrane vesicles called autophagosomes, which segregate cytoplasmic material randomly or selectively (Ohsumi, 2014). However, the purpose of autophagy is not simply to eliminate material. Instead, autophagy is a dynamic recycling system that generates new building blocks and energy for cell renewal and homeostasis (Mizushima and Komatsu, 2011). During induction of autophagy, the demand for membranes is enormous, and one of the main questions in the field concerns the origin of such membranes; almost every organelle is involved in this role (Reggiori, 2006). The early secretory pathway may also be a source of autophagosome membranes (Hamasaki et al., 2003).
Studies in recent decades have shown that homeostasis of autophagy is essential for the growth and infection processes of plant pathogenic fungi (Liu et al., 2012). In M. oryzae, knockout of autophagy-associated genes (e.g., MoATG1–10, MoATG12, MoATG15–18) is known to result in a loss of pathogenicity (Hamasaki et al., 2003; Liu et al., 2007; 2012; Dong et al., 2009; Kershaw and Talbot, 2009; Lu et al., 2009), and the process of autophagy is usually found to be decreased or blocked. Many proteins regulate the homeostasis of autophagy in rice blast fungus. MoVast1 is a novel sterol transfer protein that negatively regulates autophagy through MoTor in M. oryzae (Zhu et al., 2021), and MoOpy2 acts as a novel autophagy suppressor by regulating MoTor activity to inhibit autophagy (Cai et al., 2022).
Rab guanosine triphosphatases are critical regulators of membrane traffic, mediating various events such as membrane fusion and vesicle tethering. These molecular switches cycle back and forth between inactive (guanosine diphosphate [GDP]-bound) and active (guanosine triphosphate [GTP]-bound) conformations. The Golgi apparatus and endoplasmic reticulum–Golgi apparatus transport require yeast Rab Ypt1 (Segev et al., 1988), and Ypt1 requires transport protein particle (TRAPP) to act as the multimeric guanine nucleotide exchange factor (GEF) (Jones et al., 2000). The TRAPP complex also plays a vital role in Golgi apparatus function (Cai et al., 2008). Recently, we noticed two consecutive structural biology publications that focused on the TRAPPIII complex. They described a membrane-anchoring mechanism for yeast TRAPPIII and the large subunits that define metazoan TRAPPIII, respectively (Galindo et al., 2021; Joiner et al., 2021). Trs85 acts as a specific subunit of TRAPPIII and participates in autophagy-related activities in yeasts and mammals (Meiling-Wesse et al., 2005; Nazarko et al., 2005). However, the functions of Ypt1 and Trs85 remain poorly understood in M. oryzae.
In the present study, we confirmed the interaction between Trs85 and Ypt1 and then examined how Trs85 regulates appressorium-mediated plant infection by rice blast fungus. We identified an amphipathic helix within Trs85 that is involved in M. oryzae pathogenicity. Given the importance of the Trs85–Ypt1 interaction for M. oryzae, we proposed a novel approach for design of fungicides against rice blast, and we identified SP-141, a lead compound that shows potential for control of rice blast.
Results
Infection-associated autophagy in M. oryzae requires Ypt1
Yeast Ypt1 is an essential regulator of membrane and intracellular vesicle transport, and its deletion leads to cell death (Segev et al., 1988). A recent study of Aspergillus nidulans, using rabOA136D mutants mimicking yeast ypt1A136D mutants, revealed that rabOA136D mutants displayed temperature-sensitive defects in colony growth and autophagy (Pinar et al., 2013). However, the biological functions of Ypt1 are still unclear in M. oryzae. We therefore used substitution mutations to modify the Ypt1 protein and constructed conditional ypt1A136D mutants. At 24°C, ypt1A136D mutants showed average growth and sporulation. Upon incubation at 31°C, development of aerial hyphae was retarded, and conidiation decreased. At 34°C, aerial hyphae emerged poorly (Figure 1A). We then tested the virulence of ypt1A136D mutants and found that their virulence was significantly reduced at 31°C (Figure 1B and 1C). The degradation kinetics of GFP-tagged Atg8, the yeast paralog of LC-3, are commonly used to monitor autophagy. We next expressed a GFP–Atg8 fusion protein in the ypt1A136D mutant and monitored autophagic flux. We found that KJ201 displayed standard GFP–Atg8 signals in vacuolar lumens. By contrast, vacuolar entrance of GFP–Atg8 was wholly blocked in aerial hyphae of ypt1A136D at 31°C (Figure 1D), indicating defects of GFP–Atg8 processing in the ypt1A136D mutants. At 31°C, processed GFP bands were barely detectable in ypt1A136D mutants, indicating a block of GFP–Atg8 processing (Figure 1E). We concluded that Ypt1 is essential for infection-associated autophagy in M. oryzae.
Figure 1.
Trs85 is involved in colony growth, conidiation, appressorial morphogenesis, and the Cvt pathway.
(A) Colony morphology of ypt1A136D on CM plates at different temperatures. Temperature sensitivity of the tested strains was assessed by observing colony growth on CM plates for 5 days at 24°C, 31°C, and 34°C. ypt1-C represents the complementation strain.
(B) Pathogenicity test of the temperature-sensitive strain. Susceptible rice seedlings were sprayed with conidium suspensions (5 × 104/mL) of the WT, ypt1A136D mutant, and ypt1-C at 24°C and 31°C. Photographs were taken 5 days post inoculation.
(C) Statistical analysis of lesion areas on diseased leaves. Data are presented as mean ± SD of three biologically independent samples (n.s., not significant; ∗∗P < 0.01; two-sided Student’s t-test).
(D) Western blot for monitoring of autophagic flux. The WT (KJ201) and the ypt1A136D mutant expressing GFP–Atg8 were cultured in liquid CM at 31°C for 2 days and then shifted to liquid CM-N at 31°C for 0 h, 3 h, and 6 h under highly constant vibration. Total protein lysates were fractionated with NuPAGE SDS running buffer and immunoblotted with anti-GFP antibody.
(E) Fluorescence observations for monitoring of autophagic flux. The WT (KJ201) and ypt1A136D mutant expressing GFP–Atg8 were cultured on solid CM plates for 7 days. Aerial hyphae were observed under a confocal laser-scanning microscope to monitor the vacuolar delivery of GFP–Atg8. V, vacuoles. Scale bar, 10 μm.
(F) Results of mass spectrometry analysis using Ypt1 as a bait protein. GFP–Ypt1 in M. oryzae was used as a bait protein to enrich potential interacting proteins by immunoprecipitation.
(G) GST pull-down assay for Trs85 and Ypt1 (WT/S22N/Q67L). GST-tagged proteins were detected with anti-GST antibody. FLAG-tagged proteins were detected with anti-FLAG antibody.
(H) Positive protein fragment complementation assay (PCA) for Trs85 with Ypt1 and Ypt1-GDP but not with Ypt1-GTP. YFP fluorescence is seen in mycelia co-expressing YFPN-Trs85 with Ypt1-YFPC or YFPC-Ypt1S22N but not with Ypt1Q67L. Scale bar, 10 μm.
(I) Colony morphology of M. oryzae strains on complete medium (CM) plates. The WT (KJ201), Δtrs85 mutant, and complementation strain Δtrs85-C were cultured at 24°C for 9 days.
(J) Statistical analysis of colony growth. Data are presented as mean ± SD of three biologically independent samples (∗∗∗∗P < 0.0001, two-sided Student’s t-test).
(K) Conidium statistics of tested strains. The strains were cultured at 24°C for 10 days. Data are presented as mean ± SD of three biologically independent samples (∗∗∗∗P < 0.0001, two-sided Student’s t-test).
(L) Conidium morphology and length/width statistics. The conidium morphology of tested strains is shown in the top right corner. Scale bar, 10 μm. The bottom left corner shows the aspect ratio of the conidium. Data are presented as mean ± SD of 150 biologically independent samples (∗∗∗∗P < 0.0001, two-sided Student’s t-test).
(M) Microscopy observations of appressoria from different strains. Scale bar, 10 μm.
(N) Statistics of appressorium diameter. Data are presented as mean ± SD of 150 biologically independent samples (∗∗∗∗P < 0.0001, two-sided Student’s t-test).
(O) Monitoring of the Cvt pathway by the fusion protein GFP-Ape1/Ape1-GFP. The WT (KJ201) and Δatg1 and Δtrs85 mutants expressing GFP-Ape1/Ape1-GFP were cultured in liquid CM for 2 days, then placed into fresh CM and cultured overnight. Mycelia were shifted into liquid CM-N for 0 h, 3 h, and 6 h under highly constant vibration. R, rich in nutrition; S, starvation induced. Total protein lysates were fractionated with NuPAGE SDS running buffer and immunoblotted with anti-GFP antibody.
(P) GST pull-down assay for Trs85, Ypt1 (WT/S22N/Q67L), and Atg11. GST-tagged proteins were detected with anti-GST antibody. FLAG-tagged proteins were detected with anti-FLAG antibody.
(Q) Positive PCA for Atg11 with Ypt1, Ypt1-GTP (Q67L), and Trs85 but not with Ypt1-GDP. YFP fluorescence is seen in mycelia co-expressing YFPN-Atg11 with Ypt1-YFPC, Ypt1Q67L-YFPC or Trs85-YFPC but not with Ypt1S22N. Scale bar, 10 μm.
Trs85 directly interacts with Ypt1
After dozens of knockout attempts, we realized that YPT1 might be a lethal gene in M. oryzae. We therefore used GFP–Ypt1 as bait and identified a putative protein, Trs85 (MGG_15852), via mass spectrometry (Figure 1F). The TRAPPIII complex contains all subunits required for Ypt1 GEF activity, including Trs85 (Cai et al., 2008). To determine whether Trs85 was a component of functional Ypt1 GEF in M. oryzae, we performed glutathione S-transferase (GST) pull-down and bimolecular fluorescence complementation (BiFC) assays to explore the physical interaction between Trs85 and Ypt1 in vitro and in vivo. We obtained corresponding and consistent results for the interaction between Trs85 and Ypt1. These results indicated that Trs85 interacts with Ypt1-wild type (WT) and Ypt1-GDP (S22N, inactive form of Ypt1) but not with Ypt1-GTP (Q67L, active form of Ypt1) in M. oryzae (Figure 1G and 1H). Thus, we proposed that Trs85 was a component of a Ypt1 GEF in M. oryzae.
Trs85 is involved in mycelial growth, conidiation, appressorial morphogenesis, and the Cvt pathway of M. oryzae
To understand the biological functions of Trs85 in M. oryzae, we knocked out the TRS85 gene in the WT strain KJ201 (Supplemental Figure 1) and compared the phenotypes of Δtrs85, KJ201, and a complementation strain. The Δtrs85 strain had smaller colonies and fewer conidia than the WT (Figure 1I–1K), and conidia were shorter in Δtrs85 than in the WT (Figure 1L). Appressoria of Δtrs85 were also significantly smaller than those of the WT (Figure 1M and 1N). We concluded that Trs85 is essential not only for mycelial growth and conidiation but also for morphogenesis of the conidia and appressorium.
In yeasts, most hydrolases are transported to vacuoles through a portion of the secretory route, but hydrolases such as Ape1 and Ams1 are delivered to vacuoles through the Cvt pathway (Yamasaki and Noda, 2017). To characterize the Cvt pathway in Δtrs85, we identified the counterpart of Ape1 (MGG_07536) in M. oryzae. We fused Ape1 to the C terminus of GFP using a procedure similar to that performed in yeasts (Shintani et al., 2002) and then introduced GFP-Ape1 into the WT as well as the Δatg1 and Δtrs85 mutants. We then examined GFP-Ape1 processing by western blotting. We found that cleaved GFP bands emerged under nutrient-rich and starvation conditions in the WT. By contrast, cleaved GFP signals were absent in Δatg1 under both conditions. In Δtrs85, processed GFP bands were absent under nutrient-rich conditions but present upon starvation treatment (Figure 1O). Next, we fused Ape1 to the N terminus of GFP, and western blots revealed similar defects in Ape1-GFP processing in Δtrs85 mutants under nutrient-rich conditions (Figure 1O). Atg11 is a phagophore assembly site scaffold protein required for the Cvt pathway and different types of selective autophagy (Yorimitsu and Klionsky, 2005), and a previous study demonstrated that Atg11 is a downstream effector of Ypt1 (Lipatova et al., 2012). To further verify that Trs85 is involved in the Cvt pathway in M. oryzae, we used GST pull-down and BiFC assays to explore the interactions among Ypt1, Trs85, and Atg11 in vitro and in vivo. The results showed that Atg11 interacts with Ypt1-WT and Ypt1-GTP (Q67L) but not with Ypt1-GDP (S22N) (Figure 1P and 1Q). In addition, Trs85 showed a direct interaction with Atg11 (Figure 1P and 1Q). These results indicate that Trs85 plays a vital role in the Cvt pathway, as it can interact with Atg11 directly and indirectly. We therefore conclude that loss of Trs85 seriously impairs the Cvt pathway in M. oryzae, most likely through Atg11.
Pathogenicity and infection-associated autophagy in M. oryzae require Trs85
Pathogenicity assays were performed on rice to determine whether Trs85 regulates the virulence of M. oryzae. Four days post inoculation, the mutant strain had produced only sporadic visible disease lesions, whereas symptoms of rice blast were severe on plants inoculated with WT and complementation strains (Figure 2A and 2B).
Figure 2.
Absence of Trs85 impairs macroautophagy, and overexpression of Ypt1 suppresses the defects of Δtrs85
(A) Pathogenicity test of tested strains. Susceptible rice seedlings were sprayed with conidium suspensions (5 × 104/mL) of the WT, Δtrs85 mutant, and complementation strain. 0.025% Tween 20 was used for the control. Records were collected 5 days post inoculation.
(B) Statistical analysis of lesion areas on diseased leaves. Data are presented as mean ± SD of three biological replicates (∗∗∗∗P < 0.0001, two-sided Student’s t-test).
(C) Observation of appressorium-mediated penetration of intact/abraded barley leaves. Conidium suspensions (5 × 104/mL) of the WT, Δtrs85 mutant, and complementation strain were dropped onto 7-day barley leaves, and sampling was performed every 24 h. Scale bar, 10 μm.
(D and E) Statistical analysis of appressorium-mediated penetration of intact (D) and abraded (E) barley leaves. Data are presented as mean ± SD of three biologically independent samples (∗∗∗∗P < 0.0001, two-sided Student’s t-test).
(F) Appressorium collapse of tested strains. Appressoria were treated with glycerol for 1 min. The conidia were induced on a hydrophobic plastic coverslip at 22°C for 24 h. Scale bar, 10 μm.
(G) Statistical analysis of the rate of appressorium collapse in the tested strains. Data are presented as mean ± SD of three biological replicates (∗∗∗∗P < 0.0001, two-sided Student’s t-test).
(H) Statistical analysis of intracellular glycerol levels in the appressoria of KJ201 and Δtrs85. Conidia were induced on a hydrophobic plastic coverslip at 22°C for 24 h. Data are presented as mean ± SD of three biologically independent samples (∗∗∗∗P < 0.0001, two-sided Student’s t-test).
(I) Fluorescence observation for monitoring of autophagic flux. The WT (KJ201) and Δatg1 and Δtrs85 mutants expressing GFP–Atg8 were cultured on solid CM plates. Aerial hyphae picked at the colony margins were observed under a confocal laser-scanning microscope to monitor vacuolar delivery of GFP–Atg8 fluorescence. Scale bar, 10 μm.
(J) Western blot for monitoring of autophagic flux. The WT (KJ201) and Δtrs85 mutant expressing GFP–Atg8 were cultured in liquid CM for 2 days and then shifted to liquid CM-N for 0 h, 3 h, 6 h, and 12 h under highly constant vibration. Total protein lysates were fractionated with NuPAGE SDS running buffer and immunoblotted with anti-GFP antibody.
(K) Statistical analysis of colony diameter. Strains were cultured at 24°C for 10 days. Data are presented as mean ± SD of three biologically independent samples (∗∗∗∗P < 0.0001, two-sided Student’s t-test).
(L) Statistical analysis of conidiation in M. oryzae strains. Strains were cultured at 24°C for 10 days, and conidiation was recorded. Data are presented as mean ± SD of three biologically independent samples (∗∗∗∗P < 0.0001, two-sided Student’s t-test).
(M) Colony morphology of tested strains on CM plates. KJ201, Δtrs85, ypt1/Δtrs85 (WT form), ypt1/KJ201 (WT form), and Ypt1Q67L (GTP-locked form) were cultured for 10 days at 24°C.
(N) Pathogenicity test for overexpression strains. Photographs were taken 5 days post inoculation.
(O) Statistical analysis of lesion areas on diseased leaves. Data are presented as mean ± SD of three biologically independent samples (∗∗∗∗ P< 0.0001, two-sided Student’s t-test).
(P) Fluorescence observation for monitoring of autophagic flux. Scale bar, 10 μm.
(Q) Western blot for monitoring of autophagic flux. Total protein lysates were fractionated with NuPAGE SDS running buffer and immunoblotted with anti-GFP antibody.
Why did Δtrs85 almost completely lose its pathogenicity? Solid evidence has shown that the appressorium (or penetration peg) is the primary weapon with which M. oryzae breaches the tough leaf cuticle (Sakulkoo et al., 2018). In the above experiments, we found a morphological abnormality in the Δtrs85 appressorium (Figure 1M and 1N). We therefore wondered whether the abnormal appressorium could still penetrate the leaf or form a penetration peg, and we therefore prepared intact and abraded barley leaves for a pathogenicity test. The Δtrs85 appressorium could not form a penetration peg to infect intact barley leaves over 72 h (Figure 2C and 2D). By contrast, Δtrs85 and KJ201 showed similar abilities to infect abraded barley leaves, typically forming penetration pegs at 24 hours post-inoculation (hpi) (Figure 2C and 2E). We speculated that appressorium turgor was deficient in Δtrs85, and we therefore evaluated appressorium turgor indirectly using the incipient cytorrhysis test (Howard et al., 1991; de Jong et al., 1997). In 1.0 M and 1.5 M glycerol, the rate of appressorium collapse was significantly higher in Δtrs85 than in KJ201 (Figure 2F and 2G), indicating that Δtrs85 generates insufficient turgor.
Given the link between turgor and glycerol accumulation (de Jong et al., 1997), we next measured appressorial glycerol content and found that the intracellular glycerol level was significantly lower in Δtrs85 than in KJ201 at 24 hpi (Figure 2H). Unexpectedly, the extracellular glycerol content was significantly higher in Δtrs85 than in KJ201 (Supplemental Figure 2D), suggesting that the melanized cell wall of Δtrs85 may have been impaired. Collectively, these results demonstrated that loss of Trs85 seriously impairs the pathogenicity of M. oryzae, mainly by affecting appressorial turgor. We also detected defects in glycogen and lipid utilization or degradation in the mutants (Supplemental Figures 2A–2C and 3).
Figure 3.
SP-141 affects the pathogenicity of rice blast fungus
(A) Sequence alignment of TRS85 from four species. The red helix above the alignment represents the region predicted to fold as an amphipathic α helix.
(B) Colony morphology of M. oryzae strains on CM plates is shown on the left. The WT (KJ201), Δtrs85 mutant, complementation strain Δtrs85-C, Δtrs85-KO1 (truncated knockout residues 445–500), Δtrs85-KO2 (truncated knockout residues 462–477), and 3E (substitution mutations; R464E, K470E, and R470E) were cultured at 25°C for 7 days. A schematic is shown on the right.
(C) Statistical analysis of colony growth of the tested strains. Data are presented as mean ± SD of 3 biologically independent samples (∗∗∗∗P < 0.0001, two-sided Student’s t-test).
(D) Helical wheel representation of the Trs85-WT region predicted to be an amphipathic α helix. 3E mutants were constructed to invert charges and disrupt the amphipathic α helix.
(E) Pathogenicity assay for tested strains. Agar plates (diameter 5 mm) with different strains were used to fit the rice leaves. The samples were kept moisturized and incubated for 4 days at 25°C.
(F) Chemical structure of SP-141.
(G) Pathogenicity assay for SP-141. A spore suspension (1 × 105 conidia/ml) was treated with SP-141 to a final concentration of 10, 25, or 50 μM. DMSO was mixed with the same spore suspension to a final content of 5‰ as a control. The samples were kept moisturized and incubated for 3 days at 25°C.
(H) A model of the interaction between Trs85 and SP-141 after molecular dynamics (MD). The yellow dashed line represents π stacking. The 3D structure of the complex and the detailed binding mode are presented.
(I) Appressorium collapse of M. oryzae treated with 1.0 M, 1.5 M, or 2.0 M glycerol for 1 min. Spore suspensions were treated with SP-141 (50 μM). DMSO (5‰) was used as a control. The conidia were induced on a hydrophobic plastic coverslip at 22°C for 24 h. Scale bar, 10 μm.
(J) Observation of appressorium-mediated penetration of intact/abraded barley. Spore suspensions (5 × 104/mL) of the WT were treated with SP-141 (50 μM) and dropped onto a 7-day-old barley leaf. Sampling was performed every 24 h. DMSO (5‰) was used as a control. Scale bar, 10 μm.
(K) Statistical analysis of the rate of appressorium collapse after treatment with SP-141 (50 μM) or DMSO (5‰). Data are presented as mean ± SD of three biologically independent samples (∗∗∗∗P < 0.0001, ∗P < 0.1, two-sided Student’s t-test).
(L and M) Statistical analysis of appressorium-mediated penetration of intact (L) and abraded (M) barley leaves. Spore suspensions (5 × 104/mL) of the WT were treated with SP-141 (50 μM). DMSO (5‰) was used as a control. Data are presented as mean ± SD of three biologically independent samples (∗∗∗∗P < 0.0001, two-sided Student’s t-test).
Autophagy is known to play an essential role in lipid metabolism (Singh et al., 2009), and moderate autophagy contributes to energy storage and penetration peg development in M. oryzae (Kershaw and Talbot, 2009). To investigate the association between Trs85 and macroautophagy, we expressed GFP–Atg8 under its native promoter in Δtrs85 mutants and the WT. Emergence of vacuoles in aerial hyphae of the colony accompanied the vacuolar distribution of GFP–Atg8 in the WT, indicating a typical progression of autophagy. By contrast, delivery of GFP–Atg8 to vacuoles was arrested in newly generated aerial hyphae of Δtrs85 mutants. As a control, Δatg1 mutants showed defects in GFP–Atg8 vacuolar delivery (Figure 2I). We then performed western blotting to detect and quantify autophagic flux. Anti-GFP antisera detected a signal band of approximately 43 kDa and a smaller band of approximately 27 kDa, corresponding to full-length GFP–Atg8 and cleaved GFP, respectively. Autophagic flux was significantly slower in Δtrs85 than in the WT (Figure 2J), and we concluded that loss of Trs85 seriously impaired macroautophagy in M. oryzae.
The Trs85–Ypt1 module regulates infection-associated autophagy in M. oryzae
A previous study has shown that Trs85 directs Ypt1 to the phagophore assembly site (Lynch-Day et al., 2010). To explore the relationship between Trs85 and Ypt1 in vivo, we examined the temporal expression profiles of Ypt1 in KJ201 and Δtrs85 under nutrient deprivation and during conidiation. We found that absence of Trs85 affected the temporal and spatial expression of Ypt1 (Supplemental Figure 4B–4D).
To further explore the association between Ypt1 and Trs85 in M. oryzae, we overexpressed ypt1 (WT form) and ypt1Q67L (GTP-locked form) under the H3 promoter in Δtrs85; we also overexpressed ypt1 (WT form) in KJ201 as a control. Ypt1 expression in aerial hyphae was 20.0-fold, 3.6-fold, and 3.8-fold higher in the transformants compared with KJ201 (Supplemental Figure 4A). Overexpression of either the WT form Ypt1 or the GTP-locked form ypt1Q67L in Δtrs85 restored a portion of its defects (Figure 2K–2O), indicating that proper regulation of Ypt1 is associated with infection-related processes in M. oryzae. We then expressed GFP–Atg8 in ypt1/Δtrs85 and Δtrs85. Increased expression of ypt1/Δtrs85 restored transport of GFP–Atg8 into vacuolar lumens, and GFP–Atg8 processing largely recovered, as indicated by western blots (Figure 2P and 2Q). We concluded that overexpression of Ypt1 partially rescues the defects of the Δtrs85 mutant.
M. oryzae virulence requires a conserved amphipathic α helix within Trs85
A membrane-bound amphiphilic helix is a common motif in a wide variety of proteins and peptides. Amphiphilicity refers to the separation of hydrophobic and polar residues on opposite sides of the α helix, a distribution that is well suited for membrane binding (Drin and Antonny, 2010). Joiner et al. (2021) reported that anchorage of the TRAPPIII complex on the membrane and subsequent Rab1 activation require a conserved amphipathic helix in Saccharomyces cerevisiae. We selected sequences from three representative species and performed sequence alignment to determine whether there was a similar structure in M. oryzae. Amino acids 461–472 of M. oryzae Trs85 showed homology to other amphipathic α helices (Figure 3A). To test whether this putative amphipathic α helix performed a critical biological function, we attempted to knock out this region or construct substitution mutations that inverted the charge of the hydrophilic surface. We knocked out TRS85 (residues 445–500) in KJ201 and named the resulting mutant Δtrs85-KO1. To provide additional evidence, we performed targeted knockout of TRS85 (residues 462–477) in KJ201 and named this mutant Δtrs85-KO2. We also generated three substitution mutations, R464E, K470E, and R470E, to invert the charges and named this mutant 3E (Figure 3D). The truncated knockout mutants and substitution mutant showed no significant differences in colony phenotype compared with the full-length knockout mutant Δtrs85 (Figure 3B and 3C). A pathogenicity test in rice also showed that the two truncated knockout mutants and the substitution mutant lost virulence (Figure 3E). Taken together, these results confirm that the amphipathic α helix of Trs85 is required for M. oryzae pathogenicity.
SP-141 is a potential compound for control of rice blast and other plant pathogens
In the above experiments, we demonstrated that Trs85 is critical for full pathogenicity of M. oryzae. We wondered whether it would be possible to treat Trs85 as a new target for the control of rice blast. Because the exact crystal structure of Trs85 in M. oryzae remains unresolved, we attempted to predict its protein structure with I-TASSER (https://zhanggroup.org//I-TASSER/) and use this structure for subsequent model optimization. However, the predicted Trs85 protein still contained multiple irrational structures. We therefore used molecular dynamics (MD) simulations to optimize the protein model to minimum energy and steady state (Supplemental Figure 5).
We obtained the top 200 ranking compounds by virtual screening, and we selected the final 10 compounds on the basis of energy scoring and evaluation of critical residues in the active site (Supplemental Figure 6A and 6B). We then used in vivo pathogenicity assays to test these compounds and found that SP-141 significantly inhibited M. oryzae infection at a concentration of 50 μM (Figure 3F and 3G). In this experiment, we re-docked SP-141 into the theoretical active site of modeled Trs85 for repeat validation. The molecular docking results showed strong binding interactions between SP-141 and Trs85 (Supplemental Figure 6C). To further investigate the interaction of SP-141 with Trs85, we performed a 500-ns MD simulation of the Trs85–SP141 complex using Desmond (Schrödinger, New York, NY, USA). The simulated binding mode of SP-141 with Trs85 showed that the potent compound could bind well to a hydrophobic pocket consisting of several aromatic amino acids (Figure 3H). The naphthalene ring formed a sandwich-like π–π interaction with TRP-472 and PHE-475. TRP-472 also formed T-shaped π–π interactions with another segment of carbazole. In addition, the carbazole ring formed another T-shaped π–π interaction with PHE-492, and its two conjugated benzene rings also formed π–π interactions with HIS-533 (Figure 3H). Together, these interactions may contribute to stabilization of SP-141 in the Trs85 active site.
To further explore the effects of SP-141 on M. oryzae, we induced appressoria treated with different concentrations of SP-141. The results showed that SP-141 had no significant effect on appressorium formation (Supplemental Figure 7A), and we suspected that SP-141 instead influences formation of the penetration peg. A pathogenicity assay of barley leaves showed that conidia treated with 50 μM SP-141 still infected abraded barley, but the intact barley leaf cuticle remained undamaged when treated with SP-141 (Figure 3K–3M). We therefore speculated that SP-141 influenced the turgor of the appressorium. To confirm this conjecture, we evaluated appressorium turgor indirectly using the incipient cytorrhysis test. Under all tested glycerol concentrations, the rate of appressorium collapse was significantly higher after SP-141 treatment than in the control group (Figure 3I and 3J). These findings suggest that SP-141 interferes with appressorium turgor and pathogenicity of M. oryzae.
Given the effect of SP-141 on pathogenicity and appressorium turgor of M. oryzae, we next examined the effect of SP-141 on autophagic flux. After treatment with SP-141, most green GFP–Atg8 dots accumulated and gathered around the blue-stained vesicles. By contrast, most GFP–Atg8 fluorescence overlapped diffusely with the blue-stained vesicles in the control group (Figure 4A). This result indicated that SP-141 inhibits Atg8 fusion with vesicles in M. oryzae. To clarify this phenomenon, we performed western blots to quantify autophagic flux. Consistent with the above results, we found that autophagy slowed down to some extent in response to SP-141 treatment (Figure 4B). These data showed that SP-141 has an inhibitory effect on macroautophagy in M. oryzae.
Figure 4.
SP-141 affects autophagy and the interaction between Trs85 and Ypt1
(A) Observation of autophagic flux in living cells. Samples treated with SP-141 (50 μM) or DMSO (5‰) were observed under a microscope to monitor vacuolar delivery of GFP–Atg8 fluorescence. Blue 7-amino-4-chloromethylcoumarin (CMAC) staining was used to mark the vacuole. Scale bar, 10 μm.
(B) Western blot for monitoring of autophagic flux. Samples were treated with SP-141 (50 μM). DMSO (5‰) was used as a control. Total protein lysates were fractionated with NuPAGE SDS running buffer and immunoblotted with anti-GFP antibody.
(C) PCA for Trs85 and Ypt1 treated with SP-141 (50 μM). YFP fluorescence tended to exist as separate dots in the DMSO (5‰) treatment but tended to accumulate in clusters in the SP-141 (50 μM) treatment. The red box indicates the analysis region for fluorescence intensity. Fluorescence intensity was analyzed using ImageJ.
(D) The number of fluorescent dots in YFPN-Trs85+Ypt1-YFPC strains treated with SP-141. The fluorescent dots were counted in each cell. Data are presented as dot numbers of 59 independent samples (∗∗P < 0.01, two-sided Student’s t-test).
(E) GST pull-down assay for Trs85 and Ypt1 with different concentrations of SP-141. GST-tagged proteins were detected with anti-GST antibody. His-tagged proteins were detected with anti-His antibody.
The compound SP-141, screened based on the target Trs85 protein, should theoretically bind to the amphipathic α helix. We inferred that the TRAPPIII complex may un-anchor from the membrane, ultimately leading to inhibition of the Trs85–Ypt1 interaction. We therefore performed BiFC to verify the effect of SP-141 on the Trs85–Ypt1 interaction in vivo. As shown in Figure 4C, we found abnormalities in yellow fluorescent protein (YFP) fluorescence localization. After treatment with 5‰ DMSO, fluorescence tended to exist as separate dots. However, after treatment with 50 μM SP-141, fluorescence tended to accumulate in clusters (Figure 4C). We also counted the number of dots in each mycelial cell and found that there were significantly fewer dots in the SP-141 group than in the control group (Figure 4D). We then performed a GST pull-down assay to verify the effect of SP-141 on the Trs85–Ypt1 interaction in vitro. As shown in Figure 4E, SP-141 interfered with the Trs85–Ypt1 interaction at a concentration of 10 μM; however, increasing concentrations did not completely block this interaction. On the basis of these results, we deduced that SP-141 influences the interaction between Trs85 and Ypt1 in M. oryzae.
We performed pot experiments to test whether SP-141 can effectively control rice blast disease under cultivation conditions. First, we tested the effect of different concentrations of SP-141 on rice blast. The results showed that 50 μM SP-141 almost completely eliminated the occurrence of rice blast, and even 25 μM showed a significant effect (Figure 5A and 5B). To explore the application timing of SP-141, we next tested four different procedures: (1) application of SP-141 (50 μM) 72 h before spore inoculation, (2) application of SP-141 (50 μM) 24 h before spore inoculation, (3) simultaneous application of spores and SP-141 (50 μM), and (4) application of SP-141 (50 μM) 24 h post inoculation. All procedures worked almost equally well, except for the +24 h treatment, which showed normal symptoms of rice blast (Figure 5C and 5D). SP-141 showed no significant effects on rice. Observations of leaf sheath infection in rice also implied that SP-141 could control rice blast (Supplemental Figure 7B). These data indicated that SP-141 could effectively prevent rice blast. To determine whether SP-141 was also effective for different rice varieties and different M. oryzae WTs, we tested M. oryzae Guy11 and 70-15 on Nipponbare. The results showed that SP-141 (50 μM) effectively controlled rice blast on Nipponbare and was a strong suppressor of rice blast induced by Guy11 and 70-15 (Figure 5E and 5F).
Figure 5.
SP-141 effectively controls rice blast under cultivation conditions
(A) Effects of different concentrations of SP-141 on rice blast. Rice leaves (CO-39) were sprayed with SP-141 (25, 50, and 100 μM) and inoculated with KJ201 spores in a pot experiment. DMSO (1%) was used as a control.
(B) Statistical analysis of the effect of SP-141 (25, 50, and 100 μM). Blast disease lesion density was quantified from infected leaf segments 4 cm in length 6 days post infection. Data are presented as mean ± SD of n biologically independent leaves (n = 16 for DMSO, n = 16 for 25 μM, n = 16 for 50 μM, and n = 18 for 100 μM); ∗∗∗∗P < 0.0001, ∗P < 0.1; two-sided Student’s t-test).
(C) Effects of different SP-141 application procedures on rice blast. Rice leaves were sprayed with SP-141 (50 μM) 72 h before inoculation with KJ201 spores, 24 h before inoculation with KJ201 spores, at the same time as inoculation with KJ201 spores, and 24 h after inoculation with KJ201 spores in a pot experiment.
(D) Statistical analysis of the effects of different SP-141 application procedures. Blast disease lesion density was quantified from infected leaf segments 4 cm in length 6 days post infection. Data are presented as mean ± SD of n biologically independent leaves (n = 15 for −72 h, n = 16 for −24 h, n = 16 for 0 h, and n = 17 for +24 h); ∗∗∗∗P < 0.0001, two-sided Student’s t-test).
(E) Effect of SP-141 on different WT strains. Rice leaves (Nipponbare) were sprayed with SP-141 (50 μM) and inoculated with Guy11 and 70-15 spores in a pot experiment. The DMSO (1%) group was used as a negative control. The tricyclazole group was used as a commercial fungicide control.
(F) Statistical analysis of the effect of SP-141 on different WT strains. Blast disease lesion density was quantified from infected leaf segments 4 cm in length 6 days post infection. Data are presented as mean ± SD of 12 biologically independent leaves for all groups. (∗∗∗∗P < 0.0001, two-sided Student’s t-test).
(G) The safety of SP-141 in rice. Effects of 25 μM, 50 μM, and 100 μM SP-141 on seed germination rate and plant height are shown. The DMSO (1%) group was used as a control. The tricyclazole (2 g/l) group was used as a commercial fungicide control.
To assess the safety of SP-141 on rice, we performed a rice seed germination test and a rice pot experiment. Even a high concentration of SP-141 (100 μM) had no significant negative effect on seed germination rate (Figure 5G; Supplemental Table 1). SP-141 (100 μM) also had no significant negative effects on plant height or fresh weight (Figure 5G; Supplemental Table 1). Taken together, these results indicated that SP-141 was safe for rice within the effective dose.
To explore whether SP-141 is a potential broad-spectrum antifungal agent, we grew different WT strains of M. oryzae and four plant pathogens on complete medium (CM) plates treated with 50 μM SP-141. The inhibition rates were up to 31.4%, 27.6%, and 47.5% for strains KJ201, Guy11, and 70-15, respectively (Figure 6A and 6B). SP-141 (50 μM ) also showed 17.3%, 14.6%, 45.8%, and 50.5% inhibition rates for Botrytis cinerea, Fusarium graminearum, Alternaria alternata, and Colletotrichum spp. (Figure 6C and 6D). SP-141 completely inhibited appressorium formation of Colletotrichum spp. (Supplemental Figure 7C). These results demonstrate that SP-141 has the potential to serve as a broad-spectrum antifungal agent that inhibits M. oryzae and other plant pathogens.
Figure 6.
SP-141 inhibits mycelial growth of fungal pathogens
(A) WT M. oryzae grown on CM treated with 50 μM SP-141. WT KJ201, Guy11, and 70-15 were cultured at 24°C for 6 days.
(B) Statistical analysis of WT colony growth. Data are presented as mean ± SD of three biologically independent samples.
(C) Various plant pathogenic fungi grown on CM treated with 50 μM SP-141. B. cinerea, F. graminearum, A. alternata, and Colletotrichum spp. were cultured at 24°C.
(D) Statistical analysis of colony growth of other plant pathogenic fungi. Data are presented as mean ± SD of three biologically independent samples.
Discussion
In this work, we found that Ypt1 was critical for pathogenicity and autophagy in M. oryzae. We then revealed the mechanism by which Trs85 regulates autophagy and virulence via Ypt1 in M. oryzae. These findings support a model in which the Trs85–Ypt1 module regulates virulence, mainly by modulating the homeostasis of autophagy in M. oryzae (Figure 7A). In addition, we demonstrated that a conserved amphipathic α helix within Trs85 is essential for M. oryzae pathogenicity. Targeting the amphipathic α helix, we identified a lead compound, SP-141, that effectively inhibited infection with rice blast fungus and resulted in turgor deficiency of M. oryzae (Figure 7B). Therefore, Trs85 shows potential as a new fungicide target for rice blast fungus. The demonstration that SP-141 affects autophagy and thus impairs autophagy-related infection suggests a novel strategy for control of fungal disease.
Figure 7.
A proposed model for the role of the Trs85–Ypt1 module in M. oryzae
(A) The switch of Ypt1-GDP to Ypt1-GTP requires activation by the TRAPPIII complex and anchoring on the membrane. Subsequently, Ypt1 recruits effectors to regulate autophagy, the Cvt pathway, and the trafficking process in M. oryzae. The Trs85–Ypt1 module regulates autophagy homeostasis and thus the virulence of M. oryzae.
(B)M. oryzae infects the host and depends on a dome-shaped appressorium to form a penetration peg at the initial stage. Correct formation of the penetration peg requires the generation of very high turgor pressure in the appressorium. In the normal appressorium, Trs85, a specific subunit of the TRAPPIII complex, contains an amphipathic helix that helps the entire complex anchor to the surface of the membrane. Ypt1 is subsequently activated by TRAPPIII on the membrane. However, when Trs85 is knocked out, the rest of the TRAPPIII (TRAPPI) complex is unable to anchor on the membrane, and Ypt1 cannot be activated effectively. When a specific compound is used to bind to the amphipathic helix of Trs85, the TRAPPIII complex may un-anchor from the membrane, leading to insufficient activation of Ypt1. In this case, macroautophagy is impaired, affecting normal turgor pressure generation in the appressorium of M. oryzae.
Many autophagy-deficient mutants identified in M. oryzae (Δatg1, Δatg4, Δatg8, etc.) identified in M. oryzae show severe defects in macroautophagy and the Cvt pathway (Veneault-Fourrey et al., 2006; Liu et al., 2007, 2010). In this work, we demonstrated that the Δtrs85 mutant almost completely lost virulence (Figure 2A and 2B). Moreover, Trs85 plays a critical role in macroautophagy and the Cvt pathway in M. oryzae (Figures 1O, 2I, and 2J). We therefore suggested that Δtrs85 is a typical autophagy-associated mutant, similar to most autophagy-deficient Δatg mutants in M. oryzae. Considering the prominent phenotype of Δtrs85, we believe it is of great interest to explore the infection-related regulation mechanism of Trs85 in M. oryzae.
In budding yeast and metazoans, TRAPPIII functions at many cellular sites essential for secretion and autophagy, including preautophagosomal structures, the Golgi apparatus complex, Atg9 vesicles, and Coat Protein Complex II (COPII) vesicles (Meiling-Wesse et al., 2005; Bassik et al., 2013; Tan et al., 2013; Imai et al., 2016; Thomas et al., 2018). FgRab1, a homolog of Ypt1 in F. graminearum, has been reported to participate in pathogenicity and autophagy in F. graminearum (Yuan et al., 2022). In this study, we demonstrated the importance of the Trs85–Ypt1 module for pathogenicity and autophagy in M. oryzae. We deduced that deletion of Trs85 might prompt higher expression of Ypt1 in M. oryzae to compensate for impaired autophagy. Furthermore, Trs85 physically interacts with Ypt1-WT and Ypt1-GDP but not with Ypt1-GTP (Figure 1G and 1H), indicating that Trs85 (TRAPPIII) activates Ypt1 from the inactive form to the active form. This evidence strongly supports the theory that Trs85 affects autophagy via Ypt1 in M. oryzae. Autophagy is a critical process that determines the outcome of penetration stages in plant pathogenic fungi (Talbot and Kershaw, 2009). We therefore deduced that the Trs85–Ypt1 module regulates pathogenicity mainly by modulating the homeostasis of autophagy in M. oryzae.
A conserved amphipathic helix within Trs85 was identified in S. cerevisiae and shown to be required for TRAPPIII membrane binding and Rab1 activation (Joiner et al., 2021). In this study, we identified an amphipathic helix within Trs85 and used deletion and charge inversion to show that it was essential for M. oryzae. We suspected that the function of this amphipathic helix was conserved from S. cerevisiae to M. oryzae. Given that this helix is essential for membrane binding and Ypt1 activation, we performed compound screening based on this target (Trs85 and the amphipathic helix). Protein–protein interactions are potential drug targets in many therapeutic areas (Ran and Gestwicki, 2018). We wondered whether we could apply this strategy to fungicide development and design. Compounds were assumed to dissociate TRAPPIII from the membrane and affect Ypt1 activation. Finally, we identified a lead compound, SP-141, that significantly inhibited M. oryzae infection.
Because of worldwide concern regarding drug resistance and off-target effects, agricultural production urgently requires novel fungicide targets. Recently, herbicides that inhibit very-long-chain fatty acid biosynthesis were shown to have effective, broad-spectrum fungicidal activity against fungal pathogens (He et al., 2020). In this study, we demonstrated the antifungal activity of SP-141, which significantly impaired the appressorium turgor of rice blast fungus at a concentration of 50 μM (Figure 3I and 3J). On the basis of data reported here (Figure 6), SP-141 appears to be a potential antifungal agent for broad-spectrum control of fungal diseases, especially those caused by appressorium-dependent fungi. SP-141 is a tumor inhibitor and acts as a specific inhibitor of MDM2 in mammals (Wang et al., 2014a, 2014b). However, we did not find any protein homologs of MDM2 in M. oryzae, which suggests that SP-141 has a novel and specific mechanism in M. oryzae. We suspected that SP-141 could target the conserved amphipathic α helix within Trs85 to influence the anchoring of TRAPPIII, thus impairing autophagy-associated pathogenicity. We found that SP-141 inhibited autophagy and interfered with the Trs85–Ypt1 interaction in vivo and in vitro (Figure 4C–4E). However, there was no direct evidence that SP141 bound to Trs85 directly and blocked the interaction of Trs85 with Ypt1. Thus, target validation will be the focus of our future research. We found no obvious side effects of SP-141 on rice (Figure 5G; Supplemental Table 1) or at clinically relevant doses (40 mg/kg) in mice (Wang et al., 2014a, 2014b), indicating that it should be relatively safe for animals.
In pot experiments, SP-141 was effective only when administered prior to appressorium formation (Figure 5C and 5D), suggesting that the drug may act specifically at the appressorium formation stages. The discovery of SP-141 demonstrates that Trs85 is a novel and valuable target in M. oryzae. SP-141 has never before been considered an antifungal agent for plant disease. We believe that it shows great potential for control of rice blast and that the fungicide screening strategy used here will have broad implications for plant disease control.
Methods
Generation of mutants and complementation assays
Construction of the trs85 (MGG_15852) deletion vector was completed using modified double-joint PCR. For the complementation assay and construction of Trs85-GFP, a 4.2-kb full-length copy of the Trs85 locus, including its native promoter and coding sequence, was amplified from genomic DNA by PCR using Phanta Max Superfidelity DNA polymerase (Vazyme Biotech, Nanjing, China) and inserted into the pKD5-GFP plasmid. The partial sequences used in this study are provided in Supplemental Table 2.
Autophagy monitoring assays
To detect the autophagy process in M. oryzae, a GFP–Atg8 fusion with the native promoter was transformed into the mutant strain and KJ201 via Agrobacterium tumefaciens–mediated transformation. Aerial hyphae were picked from colonies on CM plates, and microscopy visualization of GFP–Atg8 fluorescence was performed to analyze nonselective autophagy. Transformed strains were cultured in liquid CM medium for 36–48 h at 25°C and then shifted to nitrogen starvation (CM-N or SD-N) medium to induce autophagy. Immunoblots of proteins were probed with anti-GFP antibody (GFP 1:5000; HUABIO). Quantities of free GFP and GFP–Atg8 were estimated using ImageJ.
GST pull-down assays
The cDNA fragments encoding Trs85, Ypt1-WT, Ypt1-GDP (S22N), Ypt1-GTP (Q67L), and Atg11 were amplified and inserted into the pGEX4T-1 or pET21a (modified) vector to generate fusion constructs. The constructs were transformed into Escherichia coli BL21 (DE3) cells, which were induced with 0.1 mM isopropyl β-D-thiogalactopyranoside at 18°C overnight. The bacterial suspension was collected and resuspended in lysis buffer (50 mM Tris, 0.2 M NaCl, 3% glycerol and 1 mM PMSF [pH 7.5]). After ultrasonic fragmentation and high-speed centrifugation, the GST-expression protein supernatant was incubated with 50 μL glutathione beads (Invitrogen). The beads were washed five times with lysis buffer before incubation with FLAG-expression protein supernatant. Finally, the beads were eluted with elution buffer (10 mM Glutathione (GSH), 50 mM Tris [pH 8.0]). The recombinant proteins were detected with anti-GST and anti-FLAG antibodies (HUABIO) by western blotting.
BiFC assays
The cDNA fragments encoding Trs85, Ypt1-WT, Ypt1-GDP (S22N), Ypt1-GTP (Q67L), and Atg11 were amplified and inserted into the pKD5-YFPC or pKD5-YFPN vector. Pairs of constructs were co-transformed into KJ201 by A. tumefaciens–mediated transformation. Fluorescence localization in the mycelium was observed under a Carl Zeiss LSM 880 microscope (Göttingen, Germany).
Protein prediction and model optimization of Trs85
The Trs85 protein structure was predicted with I-TASSER (https://zhanggroup.org//I-TASSER/). We provided a full-length trs85 coding sequence for prediction. MD simulation of protein–compound complexes was then performed with the Desmond 2020 module (Schrödinger). The complex was tested for 200 ns using MD. As shown in Supplemental Figure 5C, the root-mean-square deviation (RMSD) reflects the stability of the protein, and the larger the RMSD, the more unstable the protein. The Trs85 protein had an average RMSD of less than 9 Å and reached equilibrium at about 30 ns. The root-mean-square-fluctuation (RMSF) reflects the conformational changes of each amino acid of the protein, and some of the amino acid conformations fluctuate considerably, which may be an essential reason for the significant changes in RMSD of the protein (Supplemental Figure 5C).
The predicted Trs85 and optimized Trs85 MD models were evaluated in SAVES v.6.0 (https://saves.mbi.ucla.edu). Model Trs85-MD was evaluated by PROCHECK to generate Ramachandran plots (Supplemental Figure 5B). Ramachandran plots showed that the probability of amino acids falling into the core regions of template Trs85 and Trs85-MD was 56.8% and 76.8%, respectively. The possibility of falling into the reasonable area was 99.3% and 99.4%, respectively. The G-factor values of the Trs85-MD template were all greater than −0.5, indicating that the model quality was good (Supplemental Table 3). Moreover, the ERRAT fraction of Trs85-MD was higher than this threshold value (Supplemental Table 4). The optimized protein structure we obtained was basically reasonable (Supplemental Figure 5A).
Structure-based virtual screening
A total of 3961 compounds were provided by Apexbio and MedChemExpress. In total, 1971, 1170, and 820 compounds were tested from the US Food and Drug Administration approved drug library, the natural product library, and the autophagy compound library, respectively. All compounds were prepared with the LigPrep module (Schrödinger), and the protonated states were predicted at pH 7.0 ± 2.0. The Trs85-MD protein structure was prepared using the Protein Preparation Wizard (Madhavi Sastry et al., 2013) (Schrödinger). The Schrödinger modules Glide SP and Glide XP were used for the docking procedure. All calculation parameters in this process followed the default setting. The virtual screening scores are organized in Supplemental Table 5.
Safety of SP-141 in rice
Rice seeds were soaked in three concentrations of SP-141 for 2 days (Supplemental Table 1). Rice seeds treated with DMSO (1%) were used as negative controls, and seeds treated with tricyclazole (2 g/l) were used as commercial fungicide controls. All seeds were then allowed to germinate for 1 day, and germinated seeds (as well as ungerminated seeds from the tricyclazole treatment) were sown in plastic pots filled with nursery soil (15 seeds per pot). The seedlings were maintained in the greenhouse. After 24 days, the height and fresh weight of each plant were measured and averaged. There were three replicates of each concentration, and the experiment was repeated twice.
Statistical analysis
For statistical analyses, at least three independent experiments were performed. Statistical analyses were performed using GraphPad Prism 8. For comparisons between two groups, P values were determined by two-tailed Student’s t-tests: ∗P < 0.05, ∗∗P < 0.01, ∗∗∗P < 0.001, ∗∗∗∗P < 0.0001; n.s., not significant. Correlation coefficients were determined using Pearson’s rank correlation test.
Funding
This study was supported by the Key Research and Development Project of Zhejiang Province, China (2021C02010); the National Natural Science Foundation of China (32270201, 31972216, and 31970140); and the Special Project for the Selection and Breeding of New Agricultural Varieties in Zhejiang Province, China (2021C02064). This work was also supported by a grant, Organism Interaction, from Zhejiang Xianghu Laboratory (to F.-C.L.).
Author contributions
X.-Y.W. and B.D. designed the experiments. X.-Y.W. and B.D. conducted the experiments. F.-C.L., X.-H.L., and J.-P.L. directed the project. X.-Y.W., B.D., X.-M.Z., Y.-Y.C., B.Y., J.-L.C., F.X., J.-D.B., L.L., and Y.W. analyzed the data and wrote the manuscript. All authors read and approved the manuscript.
Acknowledgments
We are grateful to Dr. Akinori Yamasaki at the Cell Biology Center, Institute of Innovative Research, Tokyo Institute of Technology for providing the Ape1 antibody. We are grateful to China Pharmaceutical University for providing molecular docking software. We are grateful to Dr. Yonghwan Lee at Seoul National University for providing the KJ201 strain. We thank Dr. Zhiping Deng for advice regarding western blots, and Dr. Heng Xu and Dr. Liangchao Wang for helpful discussions. We also wish to thank Xi-Jiao Song for technical assistance with confocal microscopy analysis. No conflict of interest is declared.
Published: September 27, 2023
Footnotes
Published by the Plant Communications Shanghai Editorial Office in association with Cell Press, an imprint of Elsevier Inc., on behalf of CSPB and CEMPS, CAS.
Supplemental information is available at Plant Communications Online.
Contributor Information
Xiao-Hong Liu, Email: xhliu@zju.edu.cn.
Fu-Cheng Lin, Email: fuchenglin@zju.edu.cn.
Supplemental information
References
- Bassik M.C., Kampmann M., Lebbink R.J., Wang S., Hein M.Y., Poser I., Weibezahn J., Horlbeck M.A., Chen S., Mann M., et al. A Systematic Mammalian Genetic Interaction Map Reveals Pathways Underlying Ricin Susceptibility. Cell. 2013;152:909–922. doi: 10.1016/j.cell.2013.01.030. [DOI] [PMC free article] [PubMed] [Google Scholar]
- Cai Y., Chin H.F., Lazarova D., Menon S., Fu C., Cai H., Sclafani A., Rodgers D.W., De La Cruz E.M., Ferro-Novick S., et al. The Structural Basis for Activation of the Rab Ypt1p by the TRAPP Membrane-Tethering Complexes. Cell. 2008;133:1202–1213. doi: 10.1016/j.cell.2008.04.049. [DOI] [PMC free article] [PubMed] [Google Scholar]
- Cai Y.Y., Wang J.Y., Wu X.Y., Liang S., Zhu X.M., Li L., Lu J.P., Liu X.H., Lin F.C. MoOpy2 is essential for fungal development, pathogenicity, and autophagy in Magnaporthe oryzae. Environ. Microbiol. 2022;24:1653–1671. doi: 10.1111/1462-2920.15949. [DOI] [PubMed] [Google Scholar]
- Dong B., Liu X.-H., Lu J.-P., Zhang F.-S., Gao H.-M., Wang H.-K., Lin F.-C. MgAtg9 trafficking in Magnaporthe oryzae. Autophagy. 2009;5:946–953. doi: 10.4161/auto.5.7.9161. [DOI] [PubMed] [Google Scholar]
- Drin G., Antonny B. Amphipathic helices and membrane curvature. FEBS Lett. 2010;584:1840–1847. doi: 10.1016/j.febslet.2009.10.022. [DOI] [PubMed] [Google Scholar]
- Galindo A., Planelles-Herrero V.J., Degliesposti G., Munro S. Cryo-EM structure of metazoan TRAPPIII, the multi-subunit complex that activates the GTPase Rab1. EMBO J. 2021;40 doi: 10.15252/embj.2020107608. [DOI] [PMC free article] [PubMed] [Google Scholar]
- Hamasaki M., Noda T., Ohsumi Y. The Early Secretory Pathway Contributes to Autophagy in Yeast. Cell Struct. Funct. 2003;28:49–54. doi: 10.1247/csf.28.49. [DOI] [PubMed] [Google Scholar]
- He M., Su J., Xu Y., Chen J., Chern M., Lei M., Qi T., Wang Z., Ryder L.S., Tang B., et al. Discovery of broad-spectrum fungicides that block septin-dependent infection processes of pathogenic fungi. Nat. Microbiol. 2020;5:1565–1575. doi: 10.1038/s41564-020-00790-y. [DOI] [PubMed] [Google Scholar]
- Howard R.J., Ferrari M.A., Roach D.H., Money N.P. Penetration of hard substrates by a fungus employing enormous turgor pressures. Proc. Natl. Acad. Sci. USA. 1991;88:11281–11284. doi: 10.1073/pnas.88.24.11281. [DOI] [PMC free article] [PubMed] [Google Scholar]
- Imai K., Hao F., Fujita N., Tsuji Y., Oe Y., Araki Y., Hamasaki M., Noda T., Yoshimori T. Atg9A trafficking through the recycling endosomes is required for autophagosome formation. J. Cell Sci. 2016;129:3781–3791. doi: 10.1242/jcs.196196. [DOI] [PubMed] [Google Scholar]
- Joiner A.M., Phillips B.P., Yugandhar K., Sanford E.J., Smolka M.B., Yu H., Miller E.A., Fromme J.C. Structural basis of TRAPPIII-mediated Rab1 activation. EMBO J. 2021;40 doi: 10.15252/embj.2020107607. [DOI] [PMC free article] [PubMed] [Google Scholar]
- Jones S., Newman C., Liu F., Segev N. The TRAPP Complex Is a Nucleotide Exchanger for Ypt1 and Ypt31/32. MBoC. 2000;11:4403–4411. doi: 10.1091/mbc.11.12.4403. [DOI] [PMC free article] [PubMed] [Google Scholar]
- de Jong J.C., McCormack B.J., Smirnoff N., Talbot N.J. Glycerol generates turgor in rice blast. Nature. 1997;389:244. [Google Scholar]
- Kershaw M.J., Talbot N.J. Genome-wide functional analysis reveals that infection-associated fungal autophagy is necessary for rice blast disease. Proc. Natl. Acad. Sci. USA. 2009;106:15967–15972. doi: 10.1073/pnas.0901477106. [DOI] [PMC free article] [PubMed] [Google Scholar]
- Lipatova Z., Belogortseva N., Zhang X.Q., Kim J., Taussig D., Segev N. Regulation of selective autophagy onset by a Ypt/Rab GTPase module. Proc. Natl. Acad. Sci. USA. 2012;109:6981–6986. doi: 10.1073/pnas.1121299109. [DOI] [PMC free article] [PubMed] [Google Scholar]
- Liu T.-B., Liu X.-H., Lu J.-P., Zhang L., Min H., Lin F.-C. The cysteine protease MoAtg4 interacts with MoAtg8 and is required for differentiation and pathogenesis in Magnaporthe oryzae. Autophagy. 2010;6:74–85. doi: 10.4161/auto.6.1.10438. [DOI] [PubMed] [Google Scholar]
- Liu X.-H., Gao H.-M., Xu F., Lu J.-P., Devenish R.J., Lin F.-C. Autophagy vitalizes the pathogenicity of pathogenic fungi. Autophagy. 2012;8:1415–1425. doi: 10.4161/auto.21274. [DOI] [PubMed] [Google Scholar]
- Liu X.-H., Lu J.-P., Zhang L., Dong B., Min H., Lin F.-C. Involvement of a Magnaporthe grisea Serine/Threonine Kinase Gene, Mg ATG1 , in Appressorium Turgor and Pathogenesis. Eukaryot. Cell. 2007;6:997–1005. doi: 10.1128/EC.00011-07. [DOI] [PMC free article] [PubMed] [Google Scholar]
- Lu J.-P., Liu X.-H., Feng X.-X., Min H., Lin F.-C. An autophagy gene, MgATG5, is required for cell differentiation and pathogenesis in Magnaporthe oryzae. Curr. Genet. 2009;55:461–473. doi: 10.1007/s00294-009-0259-5. [DOI] [PubMed] [Google Scholar]
- Lynch-Day M.A., Bhandari D., Menon S., Huang J., Cai H., Bartholomew C.R., Brumell J.H., Ferro-Novick S., Klionsky D.J. Trs85 directs a Ypt1 GEF, TRAPPIII, to the phagophore to promote autophagy. Proc. Natl. Acad. Sci. USA. 2010;107:7811–7816. doi: 10.1073/pnas.1000063107. [DOI] [PMC free article] [PubMed] [Google Scholar]
- Sastry G.M., Adzhigirey M., Day T., Annabhimoju R., Sherman W. Protein and ligand preparation: parameters, protocols, and influence on virtual screening enrichments. J. Comput. Aided Mol. Des. 2013;27:221–234. doi: 10.1007/s10822-013-9644-8. [DOI] [PubMed] [Google Scholar]
- Meiling-Wesse K., Epple U.D., Krick R., Barth H., Appelles A., Voss C., Eskelinen E.L., Thumm M. Trs85 (Gsg1), a Component of the TRAPP Complexes, Is Required for the Organization of the Preautophagosomal Structure during Selective Autophagy via the Cvt Pathway. J. Biol. Chem. 2005;280:33669–33678. doi: 10.1074/jbc.M501701200. [DOI] [PubMed] [Google Scholar]
- Mizushima N., Komatsu M. Autophagy: Renovation of Cells and Tissues. Cell. 2011;147:728–741. doi: 10.1016/j.cell.2011.10.026. [DOI] [PubMed] [Google Scholar]
- Nazarko T.Y., Huang J., Nicaud J.-M., Klionsky D.J., Sibirny A.A. Early Secretory Pathway Gene TRS85 is Required for Selective Macroautophagy of Peroxisomes in Yarrowia lipolytica. Autophagy. 2005;1:37–45. doi: 10.4161/auto.1.1.1512. [DOI] [PMC free article] [PubMed] [Google Scholar]
- Ohsumi Y. Historical landmarks of autophagy research. Cell Res. 2014;24:9–23. doi: 10.1038/cr.2013.169. [DOI] [PMC free article] [PubMed] [Google Scholar]
- Pinar M., Pantazopoulou A., Peñalva M.A. Live-cell imaging of Aspergillus nidulans autophagy: RAB1 dependence, Golgi independence and ER involvement. Autophagy. 2013;9:1024–1043. doi: 10.4161/auto.24483. [DOI] [PMC free article] [PubMed] [Google Scholar]
- Ran X., Gestwicki J.E. Inhibitors of protein–protein interactions (PPIs): an analysis of scaffold choices and buried surface area. Curr. Opin. Chem. Biol. 2018;44:75–86. doi: 10.1016/j.cbpa.2018.06.004. [DOI] [PMC free article] [PubMed] [Google Scholar]
- Reggiori F. Current Topics in Developmental Biology. Elsevier; 2006. Membrane Origin for Autophagy; pp. 1–30. [DOI] [PMC free article] [PubMed] [Google Scholar]
- Ryder L.S., Talbot N.J. Regulation of appressorium development in pathogenic fungi. Curr. Opin. Plant Biol. 2015;26:8–13. doi: 10.1016/j.pbi.2015.05.013. [DOI] [PMC free article] [PubMed] [Google Scholar]
- Sakulkoo W., Osés-Ruiz M., Oliveira Garcia E., Soanes D.M., Littlejohn G.R., Hacker C., Correia A., Valent B., Talbot N.J. A single fungal MAP kinase controls plant cell-to-cell invasion by the rice blast fungus. Science. 2018;359:1399–1403. doi: 10.1126/science.aaq0892. [DOI] [PubMed] [Google Scholar]
- Segev N., Mulholland J., Botstein D. The yeast GTP-binding YPT1 protein and a mammalian counterpart are associated with the secretion machinery. Cell. 1988;52:915–924. doi: 10.1016/0092-8674(88)90433-3. [DOI] [PubMed] [Google Scholar]
- Shintani T., Huang W.-P., Stromhaug P.E., Klionsky D.J. Mechanism of Cargo Selection in the Cytoplasm to Vacuole Targeting Pathway. Dev. Cell. 2002;3:825–837. doi: 10.1016/s1534-5807(02)00373-8. [DOI] [PMC free article] [PubMed] [Google Scholar]
- Singh R., Kaushik S., Wang Y., Xiang Y., Novak I., Komatsu M., Tanaka K., Cuervo A.M., Czaja M.J. Autophagy regulates lipid metabolism. Nature. 2009;458:1131–1135. doi: 10.1038/nature07976. [DOI] [PMC free article] [PubMed] [Google Scholar]
- Talbot N.J. On the Trail of a Cereal Killer: Exploring the Biology of Magnaporthe grisea. Annu. Rev. Microbiol. 2003;57:177–202. doi: 10.1146/annurev.micro.57.030502.090957. [DOI] [PubMed] [Google Scholar]
- Talbot N.J., Kershaw M.J. The emerging role of autophagy in plant pathogen attack and host defence. Curr. Opin. Plant Biol. 2009;12:444–450. doi: 10.1016/j.pbi.2009.05.008. [DOI] [PubMed] [Google Scholar]
- Tan D., Cai Y., Wang J., Zhang J., Menon S., Chou H.-T., Ferro-Novick S., Reinisch K.M., Walz T. The EM structure of the TRAPPIII complex leads to the identification of a requirement for COPII vesicles on the macroautophagy pathway. Proc. Natl. Acad. Sci. USA. 2013;110:19432–19437. doi: 10.1073/pnas.1316356110. [DOI] [PMC free article] [PubMed] [Google Scholar]
- Thomas L.L., Joiner A.M.N., Fromme J.C. The TRAPPIII complex activates the GTPase Ypt1 (Rab1) in the secretory pathway. J. Cell Biol. 2018;217:283–298. doi: 10.1083/jcb.201705214. [DOI] [PMC free article] [PubMed] [Google Scholar]
- Veneault-Fourrey C., Barooah M., Egan M., Wakley G., Talbot N.J. Autophagic Fungal Cell Death Is Necessary for Infection by the Rice Blast Fungus. Science. 2006;312:580–583. doi: 10.1126/science.1124550. [DOI] [PubMed] [Google Scholar]
- Wang W., Qin J.-J., Voruganti S., Srivenugopal K.S., Nag S., Patil S., Sharma H., Wang M.H., Wang H., Buolamwini J.K., et al. The pyrido[b]indole MDM2 inhibitor SP-141 exerts potent therapeutic effects in breast cancer models. Nat. Commun. 2014;5:5086. doi: 10.1038/ncomms6086. [DOI] [PMC free article] [PubMed] [Google Scholar]
- Wang W., Qin J.-J., Voruganti S., Wang M.-H., Sharma H., Patil S., Zhou J., Wang H., Mukhopadhyay D., Buolamwini J.K., et al. Identification of a New Class of MDM2 Inhibitor That Inhibits Growth of Orthotopic Pancreatic Tumors in Mice. Gastroenterology. 2014;147:893–902.e2. doi: 10.1053/j.gastro.2014.07.001. [DOI] [PMC free article] [PubMed] [Google Scholar]
- Yamasaki A., Noda N.N. Structural Biology of the Cvt Pathway. J. Mol. Biol. 2017;429:531–542. doi: 10.1016/j.jmb.2017.01.003. [DOI] [PubMed] [Google Scholar]
- Yorimitsu T., Klionsky D.J. Atg11 Links Cargo to the Vesicle-forming Machinery in the Cytoplasm to Vacuole Targeting Pathway. MBoC. 2005;16:1593–1605. doi: 10.1091/mbc.E04-11-1035. [DOI] [PMC free article] [PubMed] [Google Scholar]
- Yuan Y., Zhang M., Li J., Yang C., Abubakar Y.S., Chen X., Zheng W., Wang Z., Zheng H., Zhou J. The Small GTPase FgRab1 Plays Indispensable Roles in the Vegetative Growth, Vesicle Fusion, Autophagy and Pathogenicity of Fusarium graminearum. Int. J. Mol. Sci. 2022;15 doi: 10.3390/ijms23020895. [DOI] [PMC free article] [PubMed] [Google Scholar]
- Zhu X.-M., Li L., Cai Y.-Y., Wu X.-Y., Shi H.-B., Liang S., Qu Y.M., Naqvi N.I., Del Poeta M., Dong B., et al. A VASt-domain protein regulates autophagy, membrane tension, and sterol homeostasis in rice blast fungus. Autophagy. 2021;17:2939–2961. doi: 10.1080/15548627.2020.1848129. [DOI] [PMC free article] [PubMed] [Google Scholar]
Associated Data
This section collects any data citations, data availability statements, or supplementary materials included in this article.